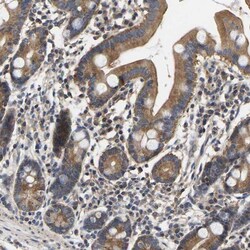
AIMP2 Antibody, Novus Biologicals 25 &mu;L; Unlabeled:Antikörper

missing translation for 'onlineSavingsMsg'
Learn More
Learn More
AIMP2 Antibody, Novus Biologicals™
Rabbit Polyclonal Antibody
Marke: Novus Biologicals NBP1-81575-25ul
Dieser Artikel kann nicht zurückgegeben werden.
Rückgaberichtlinie anzeigen
Beschreibung
AIMP2 Polyclonal specifically detects AIMP2 in Human, Mouse, Rat samples. It is validated for Western Blot, Immunohistochemistry, Immunocytochemistry/Immunofluorescence, Immunohistochemistry-Paraffin.
Spezifikation
| AIMP2 | |
| Polyclonal | |
| Western Blot 0.4 ug/ml, Immunohistochemistry, Immunocytochemistry/Immunofluorescence 1 - 4 ug/ml, Immunohistochemistry-Paraffin 1:50-1:200 | |
| aminoacyl tRNA synthase complex-interacting multifunctional protein 2, aminoacyl tRNA synthetase complex-interacting multifunctional protein 2, ARS-interacting multi-functional protein 2, JTV1JTV-1, Multisynthase complex auxiliary component p38, multisynthetase complex auxiliary component p38, p38, PRO0992, Protein JTV-1 | |
| Rabbit | |
| Affinity Purified | |
| RUO | |
| 7965 | |
| Human, Mouse, Rat | |
| IgG |
| Western Blot, Immunohistochemistry, Immunocytochemistry, Immunofluorescence, Immunohistochemistry (Paraffin) | |
| Unconjugated | |
| PBS (pH 7.2) and 40% Glycerol with 0.02% Sodium Azide | |
| AIMP2 | |
| This antibody was developed against Recombinant Protein corresponding to amino acids:APLRVELPTCMYRLPNVHGRSYGPAPGAGHVQEESNLSLQALESRQDDILKRLYELKAAVDGLSKMIQTPDADLDVTNIIQADEPTTLTTNAL | |
| 25 μL | |
| Primary | |
| Specificity of human AIMP2 antibody verified on a Protein Array containing target protein plus 383 other non-specific proteins. | |
| Store at 4C short term. Aliquot and store at -20C long term. Avoid freeze-thaw cycles. |
Berichtigung von Produktinhalten
Bitte geben Sie uns Ihr Feedback zu den Produktinhalten, indem Sie das folgende Formular ausfüllen.
Name des Produkts
For Research Use Only
Haben Sie Verbesserungsvorschläge?Übermitteln Sie eine inhaltliche Korrektur